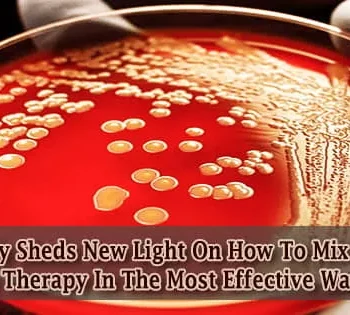

Bioengineers repurposed a 'broken' CRISPR system to create a miniature version of the genome editing tool. Its small size should make gene therapy delivery into
A new study has brought us one step closer to using viruses to fight bacterial infection and so reduce the problem of antibiotic resistance. Antibiotic resistance is emerging in a
To gain a better understanding of how global climate change will affect Earth's ecosystems, an international team of 80 researchers embarked on an unprecedented experiment: forcing the world's only enclosed
Since the turn of the century, stem cell technology has delivered on its promise to transform the healthcare industry, while applications in a variety of fields have emerged. Bioreactors, which
Reef fish like emperors, tropical snappers, and rockcods help keep crown-of-thorns starfish numbers in check on the Great Barrier Reef. According to new research, the abundance of coral-eating starfish increases